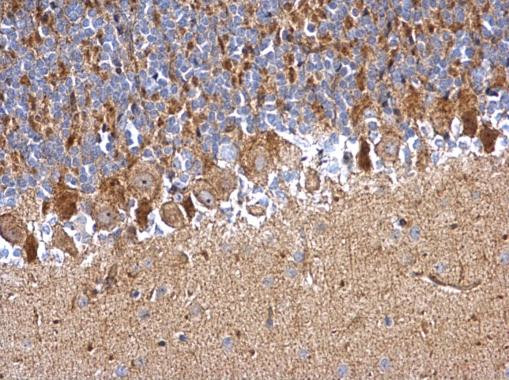
PDDC1 Antibody in Immunohistochemistry (Paraffin) (IHC (P))

Search
Invitrogen
PDDC1 Polyclonal Antibody
{{$productOrderCtrl.translations['antibody.pdp.commerceCard.promotion.promotions']}}
{{$productOrderCtrl.translations['antibody.pdp.commerceCard.promotion.viewpromo']}}
{{$productOrderCtrl.translations['antibody.pdp.commerceCard.promotion.promocode']}}: {{promo.promoCode}} {{promo.promoTitle}} {{promo.promoDescription}}. {{$productOrderCtrl.translations['antibody.pdp.commerceCard.promotion.learnmore']}}
图: 1 / 1
PDDC1 Antibody (PA5-35945) in IHC (P)

产品信息
PA5-35945
种属反应
宿主/亚型
分类
类型
抗原
偶联物
形式
浓度
规格
纯化类型
保存液
内含物
保存条件
RRID
产品详细信息
Store product as a concentrated solution. Centrifuge briefly prior to opening the vial.
Predicted reactivity: Human (93%), Mouse (86%), Rat (86%), Bovine (85%).
靶标信息
The PDDC1 (Parkinson Disease 7 Domain Containing 1) gene encodes a protein that is part of the DJ-1 protein family, known for its role in protecting cells against oxidative stress and neurodegenerative conditions. PDDC1 has been implicated in various cellular processes such as transcription regulation, response to oxidative damage, and cellular homeostasis. It is located on human chromosome 12 and is expressed in several tissues, including the brain. Although its exact function remains to be fully elucidated, PDDC1 shares homology with Parkinson's disease-associated protein DJ-1, suggesting a potential role in neuroprotection. Research indicates that PDDC1 might be involved in neural development and survival, and its dysregulation could contribute to diseases involving oxidative stress and neurodegeneration.
⚠WARNING: This product can expose you to chemicals including mercury, which is known to the State of California to cause birth defects or other reproductive harm. For more information go to www.P65Warnings.ca.gov.
仅用于科研。不用于诊断过程。未经明确授权不得转售。
篇参考文献 (0)
生物信息学
蛋白别名: Ferry endosomal RAB5 effector complex subunit 5; Fy-5; glutamine amidotransferase like class 1 domain containing 1; Glutamine amidotransferase-like class 1 domain-containing protein 1; Parkinson disease 7 domain containing 1; Parkinson disease 7 domain-containing protein 1; unnamed protein product
基因别名: FERRY5; Fy-5; GATD1; PDDC1; RGD1304836
UniProt ID: (Human) Q8NB37
Entrez Gene ID: (Human) 347862, (Rat) 309110